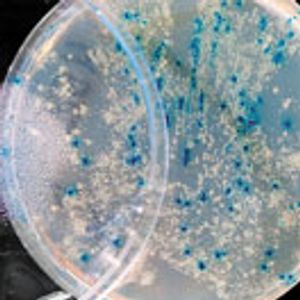
Formulating Topical Products Containing Live Microorganisms as the Active Ingredient

Case studies compare efficacy testing of preservatives for topical formulations with probiotic actives.
Jason Carbol is manager of Chemistry, Manufacturing, and Controls at Dow Development Laboratories (DDL), a division of Symbio, jcarbol@dowdevelopmentlabs.com.

Case studies compare efficacy testing of preservatives for topical formulations with probiotic actives.
Published: March 2nd 2018 | Updated: